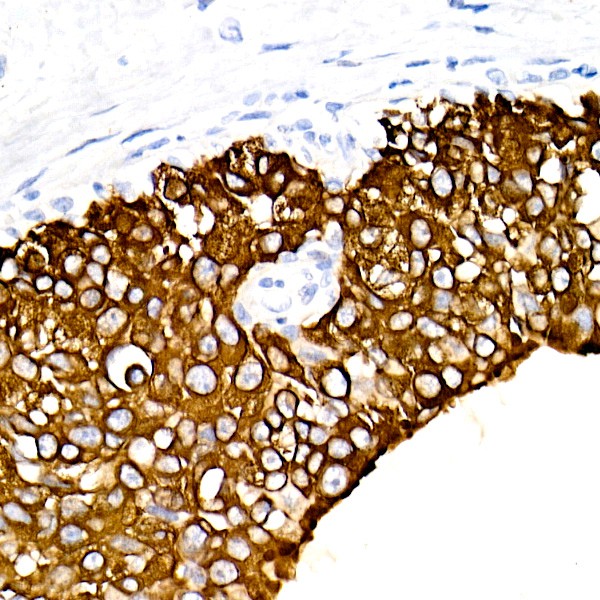
A19040: Cytokeratin 19 (CK19) Rabbit mAb
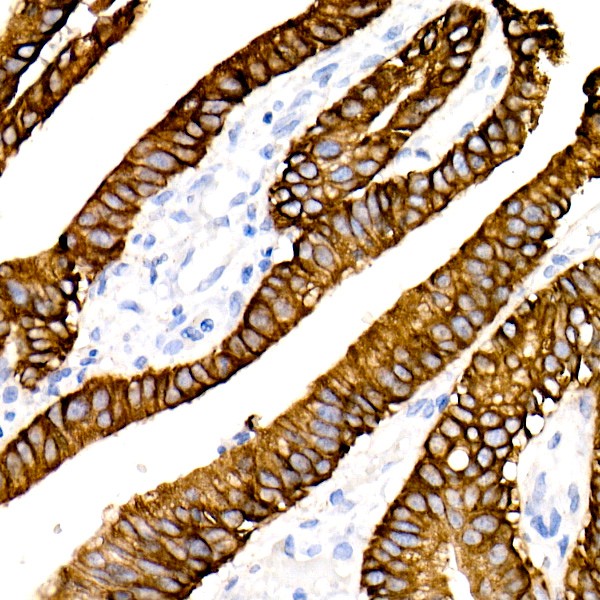
Cytokeratin 19 (CK19) Rabbit mAb (Catalog Number: A19040) Abclonal

Cytokeratin 19 (CK19) Rabbit mAb (A19040)
$148.00 – $548.00
Abclonal Cytokeratin 19 (CK19) Rabbit mAb (Catalog Number: A19040) encoded by this gene is a member of the keratin family. The keratins are intermediate filament proteins responsible for the structural integrity of epithelial cells and are subdivided into cytokeratins and hair keratins.
- Details & Specifications
- References
| Catalog No. | A19040 |
|---|---|
| Product Name | Cytokeratin 19 (CK19) Rabbit mAb (A19040) |
| Supplier Name | ABclonal, Inc. |
| Brand Name | Abclonal |
| Synonyms | K19; CK19; K1CS |
| Gene Name | KRT19 |
| Protein Name | KRT19 |
| Uniprot/Swissprot ID | P08727 |
| Gene ID | 3880 |
| Clone | ARC2811 |
| Clonality | Monoclonal |
| Source/Host | Rabbit |
| Reactivity | Human |
| Conjugate | Unconjugated |
| Note | Products will be shipped from the warehouse in Massachusetts. Promotion is running from time to time. Welcome to send a request for quote to message@sydlabs.com. |
| Order Offline | Syd Labs, Inc. 4 Avenue E, Hopkinton, MA 01748 USA. Phone: 1-617-401-8149 Fax: 1-617-606-5019 Email: message@sydlabs.com |
Description
A19040: Cytokeratin 19 (CK19) Rabbit mAb
The protein encoded by this gene is a member of the keratin family. The keratins are intermediate filament proteins responsible for the structural integrity of epithelial cells and are subdivided into cytokeratins and hair keratins. The type I cytokeratins consist of acidic proteins which are arranged in pairs of heterotypic keratin chains. Unlike its related family members, this smallest known acidic cytokeratin is not paired with a basic cytokeratin in epithelial cells. It is specifically expressed in the periderm, the transiently superficial layer that envelopes the developing epidermis. The type I cytokeratins are clustered in a region of chromosome 17q12-q21.
Immunogen Information about Cytokeratin 19 (CK19) Rabbit mAb (A19040)
Immunogen:A synthetic peptide corresponding to a sequence within amino acids 1-100 of human Cytokeratin 19 (KRT19) (KRT19) (P08727).
Sequence:MTSYSYRQSSATSSFGGLGGGSVRFGPGVAFRAPSIHGGSGGRGVSVSSARFVSSSSSGAYGGGYGGVLTASDGLLAGNEKLTMQNLNDRLASYLDKVRA
Gene ID:3880
Swiss prot:P08727
Synonyms:K19; KRT19; K1CS; Cytokeratin 19 (CK19)
Calculated MW:44kDa
Observed MW:43kDa
Images of Cytokeratin 19 (CK19) Rabbit mAb (A19040)

Western blot analysis of various lysates, using Cytokeratin 19 (CK19) Rabbit mAb (A19040) at 1:500 dilution.
Secondary antibody: HRP Goat Anti-Rabbit IgG (H+L) (AS014) at 1:10000 dilution.
Lysates/proteins: 25μg per lane.
Blocking buffer: 3% nonfat dry milk in TBST.
Detection: ECL Basic Kit (RM00020).
Negative control (NC): HeLa
Exposure time: 0.5s.

Immunohistochemistry analysis of Cytokeratin 19 (CK19) in paraffin-embedded human breast cancer using Cytokeratin 19 (CK19) Rabbit mAb (A19040) at dilution of 1:20 (40x lens).Perform high pressure antigen retrieval with 10 mM citrate buffer pH 6.0 before commencing with IHC staining protocol.

Immunohistochemistry analysis of Cytokeratin 19 (CK19) in paraffin-embedded human colon carcinoma using Cytokeratin 19 (CK19) Rabbit mAb (A19040) at dilution of 1:20 (40x lens).Perform high pressure antigen retrieval with 10 mM citrate buffer pH 6.0 before commencing with IHC staining protocol.

Immunohistochemistry analysis of Cytokeratin 19 (CK19) in paraffin-embedded human liver using Cytokeratin 19 (CK19) Rabbit mAb (A19040) at dilution of 1:20 (40x lens).Perform high pressure antigen retrieval with 10 mM citrate buffer pH 6.0 before commencing with IHC staining protocol.

Immunohistochemistry analysis of Cytokeratin 19 (CK19) in paraffin-embedded human placenta using Cytokeratin 19 (CK19) Rabbit mAb (A19040) at dilution of 1:20 (40x lens).Perform high pressure antigen retrieval with 10 mM citrate buffer pH 6.0 before commencing with IHC staining protocol.

Immunofluorescence analysis of MCF7 cells using Cytokeratin 19 (KRT19) Rabbit mAb (A19040) at dilution of 1:20 (40x lens). Secondary antibody: Cy3 Goat Anti-Rabbit IgG (H+L) (AS007) at 1:500 dilution. Blue: DAPI for nuclear staining.
Please remember our product information: Cytokeratin 19 (CK19) Rabbit mAb (Catalog Number: A19040) Abclonal